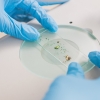
Gloved hands holding a slide under a microscope

[Stranger Danger] Will the suspect talk?
|

ForensiKit
by Crime Scene
a monthly subscription box
Explore the different techniques used in working a crime scene.
- Learn about fingerprinting, collecting shoeprints, detecting blood, & more.
- Makes a great gift for aspiring investigators, students, and other crime science buffs!
Each box (retail value $50+) comes with the same tools the pros use, directions, and learning activities.
Order now to get the June box

Get Case Credits for reading case documents, posting comments, and more.
Get Case Credits for reading case documents, posting comments, and more.